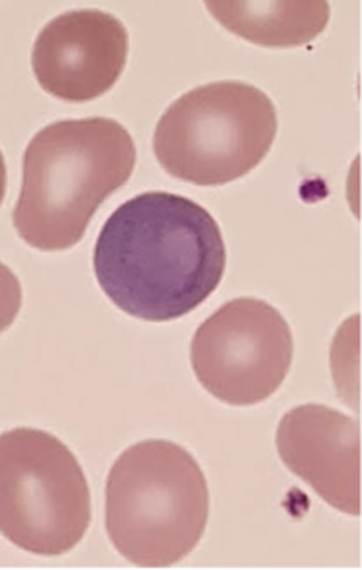

Cabot Rings
Created 26 February 2018,
Updated 6 January 2021 (revised to new format)
Updated 5 January 2026 (revised to new format and more references
added)
|
|
Look what I saw down the microscope.
Cabot rings are thin, red-violet staining, threadlike strands in the shape of
a loop or figure of eight that are found on rare occasions in red blood
cells. They are thought to be the microtubules which are all that remains of
mitotic spindles. Their presence indicates an abnormality in erythropoiesis.
There’s an entry on the things in Wikipedia (so it must be true!) They are incredibly rare; for all that I’ve seen them in text books, I can’t remember seeing any in real life
before or since. The patient presenting this had a congenital dyserthyopoetic anaemia.
|
|
But look at the case in which this ring presented (It’s not really
him from Star Trek!) . It struck me as rather interesting
that such an unusual morphological finding would occur in such a mundane
blood count; other than a mild anaemia there is not a lot wrong with the
blood count. I can only assume that a CDA on presentation would have something
in the blood count prompting preparation of a blood film. And it is amazing that although a
hundred years have passed, we still do not know the clinical significance of
Cabot ring |
|
Some More Expert Opinion…
https://imagebank.hematology.org/image/60925/cabot-ring
https://imagebank.hematology.org/image/62463/cabot-ring-in-hemolytic-anemia